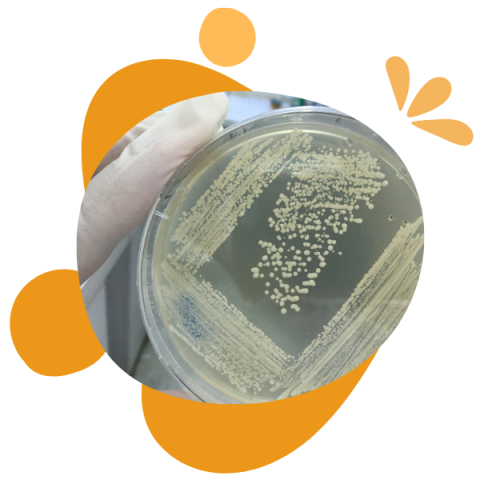
Probióticos contra Helicobacter pylori

Somos la Oficina de Transferencia y Licenciamiento de la Universidad de Concepción (OTL UdeC), el organismo encargado de promover y facilitar las relaciones entre la comunidad universitaria y su entorno, a través de la conexión del nuevo conocimiento y las capacidades de I+D de la Universidad con las necesidades del sector productivo y de la sociedad.
Cifras
424
TECNOLOGÍAS UDEC
+500
PATENTES VIGENTES
+80
CONTRATOS DE LICENCIAS
11
SPINOFF UDEC CREADAS
Actualización: mayo de 2025
Últimas noticias
Premios Ciencia con Impacto 2025
En la IX edición de los Premios Ciencia con Impacto, reconocemos a investigadoras, investigadores, emprendedores y empresarios que han destacado durante 2025 por llevar el conocimiento nacido en nuestra Universidad hacia la sociedad, generando un impacto positivo en la comunidad, o bien, en los sectores productivos.
La Oficina de Transferencia y Licenciamiento (OTL UDEC), abre desde el 10 de noviembre de 2025 hasta el viernes 05 de diciembre de 2025 el
plazo de presentación de experiencias exitosas de Transferencia de Conocimiento en el área de la Ciencias Sociales, Humanidades, Arquitectura, Urbanismo, Geografía y Educación.
La categoría Ciencias Sociales, Humanidades, Arquitectura, Urbanismo, Geografía y Educación reconoce a los casos de éxito de transferencia de nuevos conocimientos, nacidos desde procesos de investigación y desarrollo realizados por académicos e investigadores de la Universidad de Concepción y que resuelven problemas de la sociedad.
Te puede interesar
.
.
JANUS UDEC es la plataforma de capacidades de I+D de la Universidad de Concepción.
→ Revisa el video tutorial
Revisa los desafíos presentados por distintas empresas y organizaciones públicas que requieren soluciones innovadoras.
Presentamos los hitos de innovación que surgen en la Universidad de Concepción, con el propósito de generar impacto en la sociedad.
Talleres 2025

Taller 1
PROPIEDAD INTELECTUAL
Familiarizar a las y los participantes con los conceptos generales de Propiedad Intelectual (PI), el funcionamiento de la Unidad de Propiedad Intelectual y los reglamentos UdeC vigentes.. .
FECHA: miércoles 7 de mayo de 15 a 16.30 hrs.
Taller 2
TRANSFERENCIA TECNOLÓGICA (PARTE 1)
Presenta la gestión de la transferencia tecnológica. Ofrece herramientas para apoyar la transformación de resultados de investigación en productos y servicios.
FECHA: miércoles 14 de mayo de 15 a 16.30 hrs.
Taller 3
TRANSFERENCIA TECNOLÓGICA (PARTE 2)
Profundizar en las etapas del proceso de innovación en el contexto UdeC.
FECHA: miércoles 28 de mayo de 15 a 16.30 hrs.
Taller 4
EMPRENDIMIENTO TECNOLÓGICO
Potencia el desarrollo del pensamiento creativo hacia la búsqueda de oportunidades de innovación, planes y modelos de negocios viables que permitan crear emprendimientos tecnológicos.
FECHA: miércoles 4 de junio de 15 a 16.30 hrs.
¿Qué podemos hacer por ti?
Escríbenos y conoce todo lo que OTL UdeC puede ofrecer. Deja tus datos en el formulario de contacto o bien, escribe a otl@udec.cl. En 48 horas un gestor tecnológico se contactará contigo.